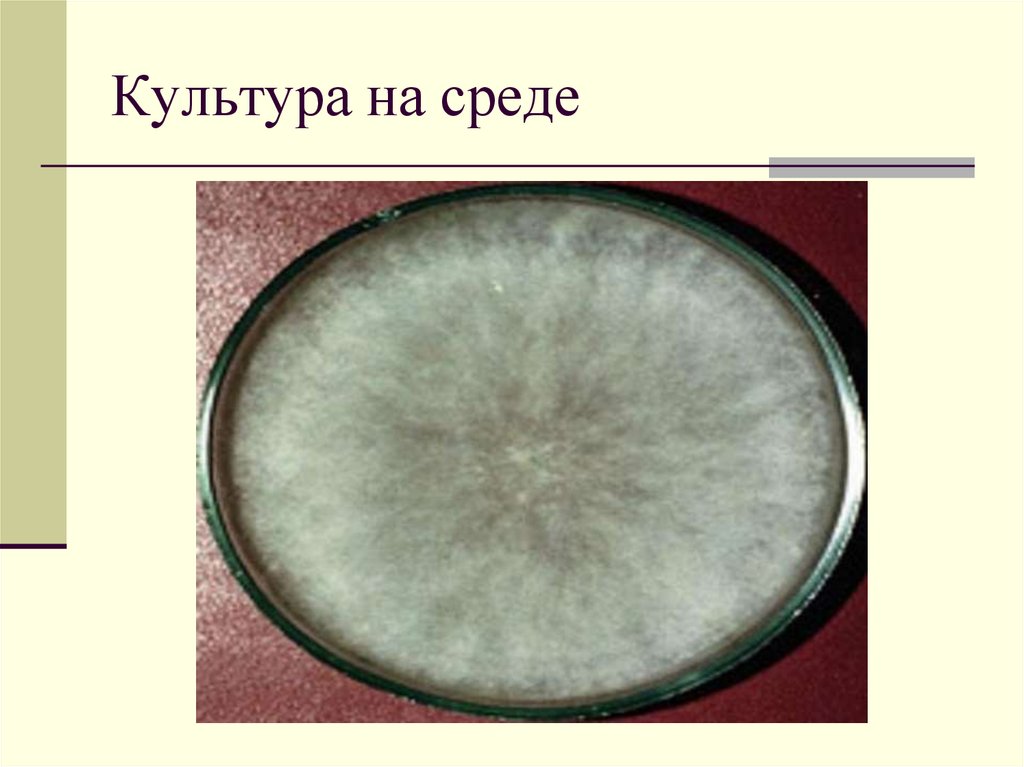
Культура на среде

Похожие презентации:
Несовершенные грибы. Отдел Анаморфные
1. НЕСОВЕРШЕННЫЕ ГРИБЫ
2. Отдел Анаморфные (Несовершенные) грибы
Deyteromycetes (Fungi imperfecti)3. Анаморфные грибы
Размножение конидиямиПоловое спороношение утрачено
Многоклеточный гаплоидный
мицелий
Некоторые не имеют никакого
спороношения (существуют в виде
стерильного мицелия и
размножаются вегетативно)
4. Отдел Анаморфные грибы
Кл. Гифомицеты (Hyphomycetes)Кл. Целомицеты (Coelomycetes)
Кл. Агономицеты (Agonomycetes) –
стерильные мицелии
5. Кл.Гифомицеты - Hyphomycetes
Конидиальное спороношениеразвивается прямо на грибнице, на
поверхность субстрата выходит в
виде налета
В основном сапротрофы, на растениях
вызывают увядание и корневые
гнили
6. Кл.Гифомицеты – Hyphomycetes:
p. Arthrobotrys – хищные грибыp.Monilia
p. Botrytis
p. Verticillium
p. Penicillium
p. Aspergillus
p. Trichoderma
p. Trichothecium
p. Cercospora
p. Helminthosporium
p. Piricularia
p. Fusarium
7. Монилиоз Monilia cinerea
МонилиальныйГниль плодов
ожог
Внезапно буреют и
засыхают цветки,
листья, молодые
побеги
Засохшие плоды и
листья долго
остаются на дереве,
не опадая
На плодах
появляется
небольшое пятно,
которое быстро
разрастается на
весь плод
Гнилые плоды
сморщиваются и
постепенно
засыхают
8. Монилиоз Monilia cinerea, M.ftuctigena
Плодовая гниль –на плоде
появляется бурое
пятно, которое
быстро
разрастается и
охватывает весь
плод. Мякоть плода
бурая,
размягченная
Монилиальный
ожог – быстрое
побурение и
9. Монилиоз
10. p. Botrytis
Вызывает:Серую гниль капусты
Серую гниль винограда
Серую гниль цитрусовых
Серую гниль коробочек хлопчатника
Серую гниль початков кукурузы и др.
11. Botrytis на винограде
12. на винограде
13. Botrytis на землянике
14.
Botrytis на розах15.
16. Botrytis на корнеплодах
17. Botrytis на томатах
18. Botrytis на томатах
19. Botrytis на томатах
20. Конидии (р. Botrytis)
21. Культура на среде
22. Цикл развития р. Botrytis
23. Р. Вертициллиум (Verticillium)
Вызывает:увядание хлопчатника
увядание клещевины
увядание подсолнечника
увядание овощных
увядание плодовых
увядание ягодных
24. Вертициллезное увядание
25. Вертициллезное увядание
26. Вертициллезное увядание
27. Вертициллезное увядание
Пожелтение и некроз листьев и увяданиерастений в поле
28. р. Cercospora (церкоспороз)
На листьях, черешках и стеблях пятна пепельногоцвета с бурой каймой
29. Р. Helminthosporium – гельминтоспориоз (полосчатая пятнистость)
30. Р. Fusarium – фузариоз колоса
31. Р. Fusarium – корневые гнили
32. Кл. Целомицеты (Coelomycetes)
Конидиеносцы расположены наповерхности плотного сплетения гиф (лож)
или внутри пикнид
Пор. Меланкониевые (Melanconiales) –
конидиеносцы на бугорке (ложе)
Пор. Сферопсидные (Sphaeropsidales) –
конидиеносцы в пикнидах
33. Пор. Меланкониевые (Melanconiales)
р.Colletotrichum – вызываетантракнозы – изъязвление
пораженных побегов, плодов, семян
34. Антракнозы
35. Антракнозы
36. Пор. Сферопсидные (Sphaeropsidales)
р. Phoma – фомозыр. Septoria – септориозы
р. Ascochyta - аскохитозы
37. Фомозы
38. Фомозы
39. Септориоз
40. Аскохитоз
41. Кл. Агономицеты –(Agonomycetes) – cтерильные мицелии
Не формируют никакого спороношенияВ цикле развития есть только грибница и
склероции
р. Sclerotium – вызывает гнили кукурузы,
подсолнечника, арахиса (из-за большого
количества черных склероциев болезнь
называют «черной гнилью»)

Биология
Биология








